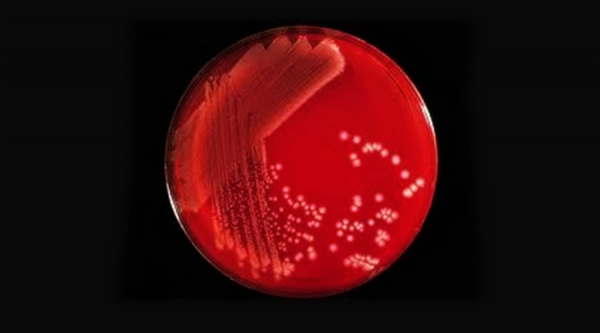
Residual Solvents Analysis

Microbial Limits Testing (MLT)
Microbial Limits Testing (MLT) is an important quality control process mandated by regulatory agencies for the assurance that human and animal use products are free from pathogenic microbial contaminants. At Chromak Research, one of the premier contract testing laboratories, we provide extensive microbial testing services to examine and ensure the microbiological safety of a variety of products.
What is Microbial Limits Testing?
Microbial Limits Testing is the quantitative and qualitative determination of microbial content in non-sterile products. It is particularly critical in pharmaceuticals, nutraceuticals, cosmetics, personal care, and medical devices where microbial contamination will jeopardize product quality, performance, and consumer safety.
MLT determines the presence and quantity of total aerobic microorganisms, yeasts, molds, and objectionable pathogens in a product. This type of microbiological analysis is not only an exercise in quality control—it’s a regulatory requirement by global pharmacopeias such as USP (United States Pharmacopeia).
Regulatory Guidelines for MLT
Chromak Research performs MLT in accordance with USP guidelines such as:
USP <60>
Detection of Burkholderia cepacia Complex (BCC). A test specifically for aqueous-based pharmaceutical and personal care products.
USP <61>
Microbiological Examination of Non-Sterile Products: Microbial Enumeration Tests. This measures total aerobic microbial count (TAMC) and total yeast and mold count (TYMC).
USP <62>
Tests for Specified Microorganisms. This detects the presence of objectionable microorganisms like Escherichia coli, Salmonella spp., Staphylococcus aureus, Pseudomonas aeruginosa, and others.
Moreover, Chromak Research is capable of conducting microbial analysis for nutraceuticals according to USP <2021> and USP <2022> to guarantee dietary supplements and herbals conform to microbiological standards.
Products We Test
Why Microbial Testing Matters
Microbial contamination at any point during production has the potential to be a serious threat to consumer health and product integrity. Compliance with regulations by using MLT guarantees your product:
Why Chromak Research for MLT?
Our highly trained microbiologists and quality control staff perform testing by qualified methods in an exceptionally well-controlled laboratory environment.
This testing is conducted following USP <60>, <61>, <62>, <2021>, and <2022>.
With the assistance of highly developed microbial testing technology, proper and timely reporting is achieved.
Flexible packages customized for your product and industry requirements.
Get in Touch
Secure the microbiological safety of your products with Microbial Limits Testing from Chromak Research. Call us today to order your test or to find out more about our full array of pharmaceutical and nutraceutical microbiological testing services.
